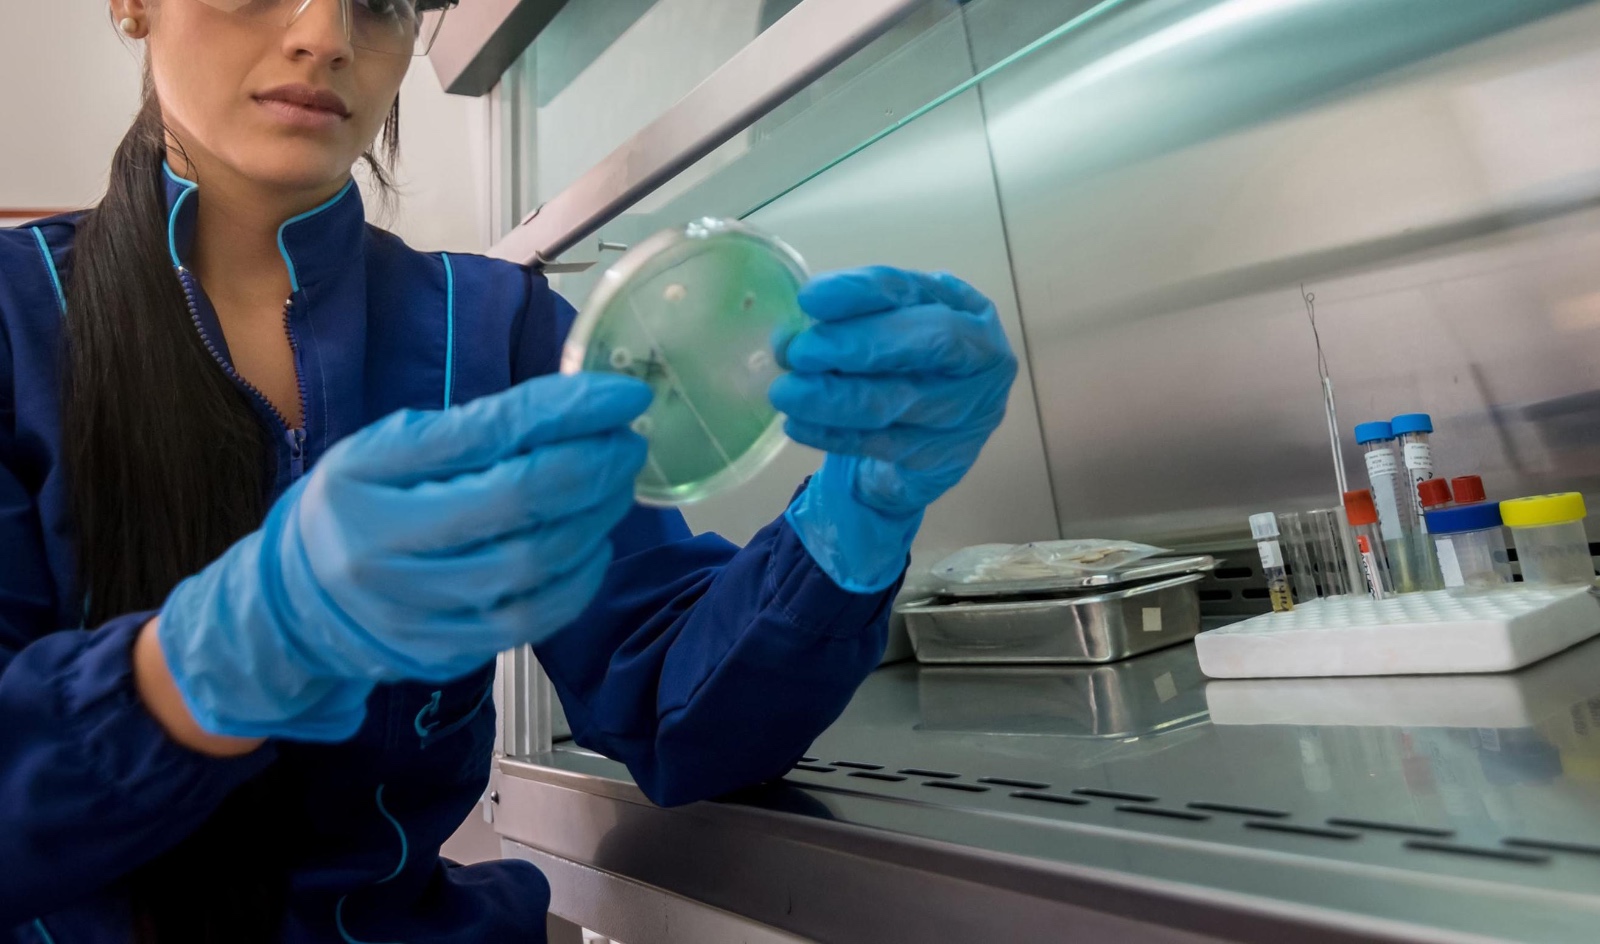
empresas involucradas

Empresas ligadas al “cártel de la sangre” mantendrían licitaciones del sector salud

Dos empresas involucradas en un esquema de colusión en el sector salud continúan recibiendo contratos públicos en 2025, de acuerdo con una investigación publicada por Reporte Índigo.
Se trata de Instrumentos y Equipos Falcón S.A. de C.V. y Arquina S.A. de C.V., compañías vinculadas al llamado “cártel de la sangre”, las cuales han obtenido 26 contratos por un monto total de 839 millones 409 mil 788 pesos, según datos de la plataforma Compras MX (Antes CompraNet).
Entre 2008 y 2015, al menos 11 empresas participaron en un modelo para simular competencia en licitaciones relacionadas con servicios integrales de laboratorio clínico y bancos de sangre en el Sistema Nacional de Salud. El expediente DE-011-2016 de la entonces Comisión Federal de Competencia Económica (Cofece) detalló la existencia de “pactos de no agresión”, reparto de contratos y ofertas coordinadas.
Estas prácticas, señaló el organismo, provocaron sobreprecios de hasta 58 por ciento y generaron un daño estimado al erario de más de mil 200 millones de pesos.
Instrumentos y Equipos Falcón, una de las principales beneficiarias este año, ha suscrito 25 contratos que suman 837 millones 55 mil 574 pesos. El más alto, por 181 millones 666 mil 364 pesos, corresponde a un servicio integral de laboratorio clínico para el ISSSTE.
En 2022, la Secretaría de la Función Pública —actual Secretaría de Anticorrupción y Buen Gobierno— la inhabilitó temporalmente por su participación en las prácticas acreditadas por Cofece, aunque actualmente mantiene contratos vigentes con vencimientos entre junio y diciembre.
Arquina S.A. de C.V., por su parte, ha obtenido en 2025 un contrato por 2 millones 354 mil 214 pesos para servicios de hemodiálisis. Esta empresa está relacionada con Disequi S.A. de C.V., firma que en 2022 fue señalada en Veracruz por presuntas irregularidades en el almacenamiento de muestras de sangre, de acuerdo con Reporte Índigo.
Ambas compañías han sido proveedoras de gobiernos estatales, incluyendo las administraciones de Omar Fayad Meneses y Julio Menchaca Salazar en Hidalgo.
Las adjudicaciones de este año cubren una gama de servicios médicos: análisis clínicos, estudios automatizados, banco de sangre, pruebas de transfusión y refacciones para equipos médicos. Según el expediente de Cofece, presentado tras una denuncia del IMSS en 2016, el esquema se sostuvo con intercambios de correos y llamadas entre empresas para repartirse procesos de contratación pública en diversos años, incluidos 2008, 2010, 2011 y 2015.
El órgano regulador consideró que estas prácticas constituyeron una de las afectaciones más relevantes en el sector salud público, con implicaciones directas sobre la asignación de recursos a servicios médicos esenciales.



